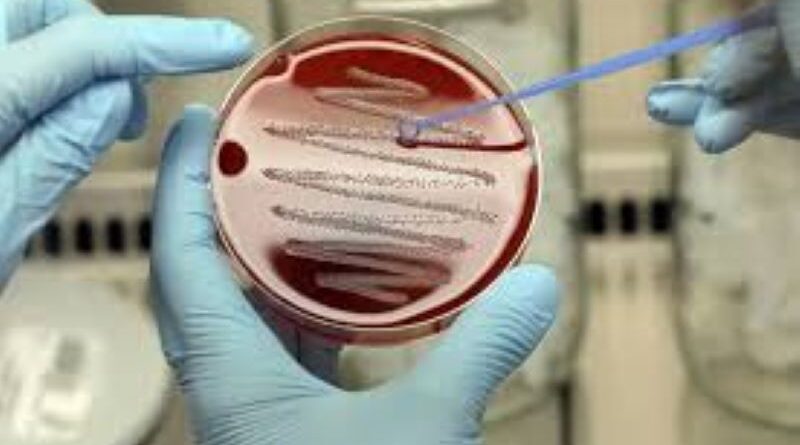

Bacteria letal se propaga en Japón rápidamente
La rápida propagación en Japón del síndrome de ‘shock’ tóxico estreptocócico, causado por una bacteria carnívora potencialmente letal, en el primer semestre de este año ya ha sumado un total de 977 casos, lo que supera los 941 del año pasado, informó Kyodo citando al Instituto Nacional de Enfermedades Infecciosas del país (NIID, por sus siglas en inglés). Este año, el mayor número de casos —145— se contabilizó en la prefectura de Tokio.
El índice de esta enfermedad registrada en 2023 se consideraba como el mayor número anual de casos contabilizados desde que se impusieron los informes obligatorios en 1999, detalló el instituto. No obstante, a principios de este mayo, en Japón se registraron 801 casos de esta patología que sumaron otros 176 en un mes.